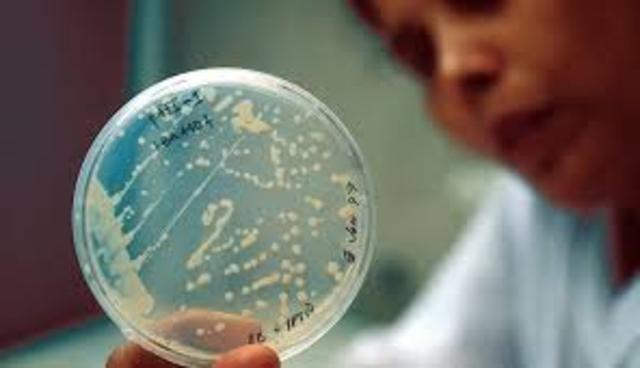
Primer trasplante de un genoma completo.

-
Aisló varias moléculas ricas en fosfato del núcleo de los glóbulos blancos, a las que llamo nucleinas.
-
Mediante la implementacion de ácido, logra romper los enlaces fosfodiester que unen a los nucleotidos de una cadena de polinucleotidos, ubicados en la "nucleina", logrando distinguir compuestos ricos en nitrógeno.
-
Descubre que la nucleina de Meishcer tenia propiedades ácidas, por lo que ahora pasa a llamarla ácidos nucleicos.
-
Su teoría cromosomica anuncia que los alelos mendelianos están ubicados en los cromosomas.
-
Identifica en los ácidos nucleicos la presencia de los azucares y las bases nitrogenadas, dando las primeras luces sobre la existencia del esqueleto azúcar - base nitrogenada.
-
Mediante experimentos realizados con bacterias de distintas cepas, Griffith logra descubrir que bacterias de una cepa eran capas de transmitir sus caracteres a otra cepa e inducir cambios transformantes en ellas.
-
Determino que el núcleo de una célula controla el desarrollo de los organismos conteniendo la información hereditaria mediante un experimento con el alga Acetabularia, en el cual la umbela podía ser removida y esta regenerada si y solo si estaba presente el núcleo en en la célula.
-
Tras su demostración sobre la naturaleza polimerica del ADN, lograron anular teorías anteriores que sugerían que cada molécula de ADN contenía solo 10 nucleotidos de longitud.
-
Antes de esto, se creía que solo los animales poseían ADN, pero tras su descubrimiento ahora se tiene una visión mas ampliada sobre la presencia de esta molécula en organismos de diferentes reinos.
-
Se basa en el principio transformador de Griffith, para mediante un experimento con virus, llegar a la conclusión de que los virus logran reproducirse gracias a inyectan su ADN en las células huésped.
-
Chargaff analiza las bases nitrogenadas del ADN en diferentes organismos, descubriendo que la cantidad de purinas y pirimidinas presentes en organismos de la misma especie se encuentran en proporciones iguales. Esto luego paso a llamarse las reglas de Chargaff.
-
A partir de estudios cristalográficos, y recopilando información de diferentes investigadores como Erwin Chargaff, proponen el modelo de doble hélice para la molécula de ADN.
-
Identifico la secuencia de unos patrones en la composición de la insulina, los cuales luego vio presentes en muchas otras proteínas, concluyendo que estas estas compuestas de unidades mas pequeñas llamadas aminoácidos.
-
-
Se logra identificar la presencia y función de esta enzima en el proceso de replicacion del ADN.
-
-
En su experimento utilizaron centrifugacion con gradientes de soluciones de cloruro de cesio, y cultivaron bacterias primero en un medio rico en nitrogeno pesado, luego las pasaron a un medio de nitrogeno ligero, y tras la centrifugacion encontraron la presencia tanto de nitrogeno pesado como de nitrogeno ligero en las moleculas de ADN de las bacterias hijas.
-
Propone que la mayor parte de la síntesis de ATP en la respiración celular viene de un gradiente electroquimico entre la membrana interna y el espacio intermembrana de la mitocondria.
-
Se demuestra que en la traducción, el ARNm es leído en sentido 5'-> 3' , induciendo la creación de una cadena polipeptidica desde el extremo amino al extremo carboxilico.
-
Marshall Nirenberg, Khorana y Ochoa trabajaron en este descubrimiento.
-
Las bacterias luego de ser infectadas por algún virus, liberan enzimas como sistema de defensa o de restricción, las cuales degradan el ADN del virus, impidiendo que estos lleguen a infectarlas.
-
Martin Temin y David Baltimore descubrieron la enzima transcriptasa inversa, su presencia en algunos virus y su función transformando ARN en ADN
-
Se descubre una de las proteínas conocidas como genes supresores de tumores, los cuales se encargan de impedir la mitosis de células encaminadas a convertirse en células cancerosas, e inclusive en algunos casos inducir a su apoptosis.
-
Gordon y Ruddler implantan ADN de embriones en los ratones.
-
Se identifican a los transposones como moleculas de ADN capaces de brincar de un lado a otro e interferir con la expresion de los genes en donde brinquen.
-
-
Esta técnica permita la amplificación de una secuencia de ADN mediante nucleotidos trifosfatados y un ADN polimerasa.
-
Con este proyecto los investigadores tienen por objetivo conocer el conjunto de genes y sus funciones en la especie humana.
-
-
-
-
Se da la clonacion del primer mamífero obtenida a partir de núcleos de células adultas.
-
-
Se identificaron las moléculas conocidas como ciclinas, y quinasas dependientes de ciclinas, las cuales controlan el ciclo celular.
-
Este trasplante se realizo de una bacteria a otra.
-
-
Eso significa
que gracias a la reprogramación celular se puede borrar la memoria del desarrollo de una célula, convirtiéndola en un tipo totalmente diferente después de haberla devuelto a su estado embrionario. Células iPS que poseen la capacidad de convertirse en cualquier tipo celular especializado.
Want to make a timeline like this?
Use Timetoast to turn dates, events, milestones, and phases into a clear visual timeline you can build and share. Timetoast is a timeline maker for work, school, research, and stories.